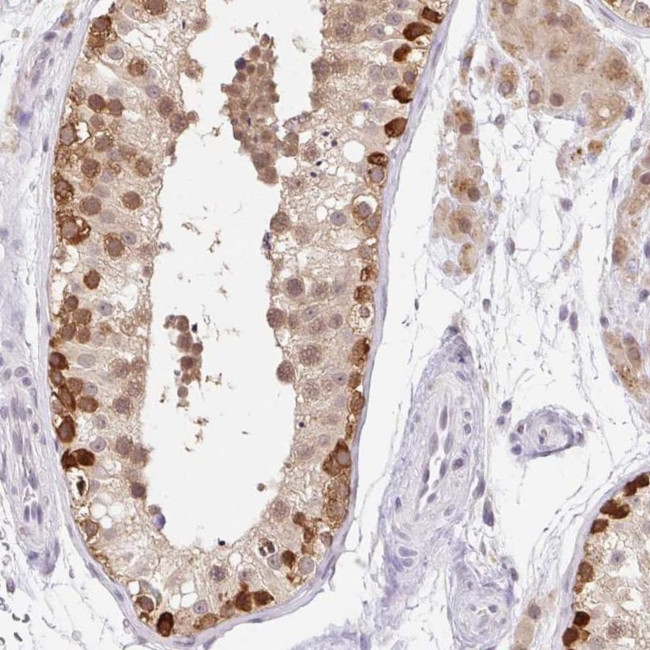
FUSIP1 Antibody in Immunohistochemistry (IHC)

Search
Invitrogen
FUSIP1 Polyclonal Antibody
{{$productOrderCtrl.translations['antibody.pdp.commerceCard.promotion.promotions']}}
{{$productOrderCtrl.translations['antibody.pdp.commerceCard.promotion.viewpromo']}}
{{$productOrderCtrl.translations['antibody.pdp.commerceCard.promotion.promocode']}}: {{promo.promoCode}} {{promo.promoTitle}} {{promo.promoDescription}}. {{$productOrderCtrl.translations['antibody.pdp.commerceCard.promotion.learnmore']}}
产品信息
PA5-62846
种属反应
宿主/亚型
分类
类型
抗原
偶联物
形式
浓度
规格
纯化类型
保存液
内含物
保存条件
运输条件
RRID
产品详细信息
Immunogen sequence: DRKTPNQMKA KEGRNVYSSS RYDDYDRYRR SRSR
Highest antigen sequence identity to the following orthologs: Mouse - 100%, Rat - 100%.
靶标信息
SRSF10 (Serine and Arginine Rich Splicing Factor 10) is a member of the SR family of RNA-binding proteins that regulates alternative pre-mRNA splicing. It contains an RNA recognition motif (RRM) and a serine/arginine-rich (RS) domain that mediates RNA binding and protein-protein interactions within the spliceosome. SRSF10 functions as a context-dependent splicing regulator, capable of promoting or repressing exon inclusion depending on cellular conditions. Notably, it undergoes phosphorylation-dependent regulation, and during cellular stress or mitosis it can shift from an activator to a repressor of splicing. SRSF10 has been implicated in cell cycle control, apoptosis, metabolic regulation, and cancer-associated splicing alterations. Formerly known as FUSIP1 (FUS-interacting protein 1), SRSF10 is widely studied for its role in dynamic and stress-responsive RNA processing.
仅用于科研。不用于诊断过程。未经明确授权不得转售。
篇参考文献 (0)
生物信息学
蛋白别名: 40 kDa SR-repressor protein; contains RNP1 and RNP2 motifs; RS domain; FUS interacting protein (serine-arginine rich) 1; FUS-interacting protein (serine-arginine rich) 2; FUS-interacting serine-arginine-rich protein 1; neural-salient SR protein; protein phosphatase 1, regulatory subunit 149; serine-arginine repressor protein (40 kDa); Serine/arginine-rich splicing factor 10; splicing factor; Splicing factor SRp38; splicing factor, arginine/serine-rich 13; Splicing factor, arginine/serine-rich 13A; SR protein; SR splicing factor 10; SRrp40; TASR; TLS-associated protein TASR; TLS-associated protein with Ser-Arg repeats; TLS-associated protein with SR repeats; TLS-associated serine-arginine protein; TLS-associated serine-arginine protein 1; TLS-associated serine-arginine protein 2; TLS-associated SR protein; unnamed protein product
基因别名: FUSIP1; FUSIP2; NSSR; PPP1R149; SFRS13; SFRS13A; SRp38; SRrp40; SRSF10; TASR; TASR1; TASR2
UniProt ID: (Human) O75494
Entrez Gene ID: (Human) 10772